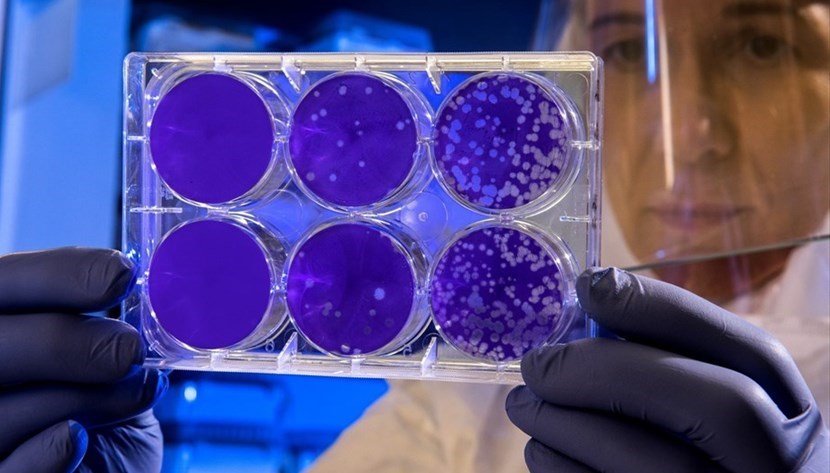
Ricerca

Ricerca © Unspalsh
Ricerca © Unspalsh
Ormai è una certezza il fatto che sta dilagando la psicosi da Coronavirus, e il Governo proprio ieri ha dichiarato lo Stato di Emergenza Sanitaria. Sarà quindi utile, tra notizie di nuovi contagi, presunti untori, economia a picco, voli bloccati e tanti altri aspetti fare un po' di chiarezza. Cercando prima di tutto di capire di cosa stiamo parlando.
Perché si chiama proprio Coronavirus?
Questa è la prima cosa su cui occorre fare chiarezza. Il nome della malattia in questione non è Coronavirus, ma 2019-nCoV . Coronavirus indica la famiglia alla quale appartiene. I Coronavirus (citiamo il Ministero della Sanità, clicca qui e qui) sono una vasta famiglia di virus, alla quale appartengono sia il comune raffreddore sia patologie più gravi (come la Sars, che però, lo precisiamo, non è legata a questa malattia). Si chiamano Coronavirus perché osservati al microscopio elettronico presentano un aspetto a corona.
Quale è il tasso di mortalità del 2019-nCoV ?
Il tasso, per fortuna, è molto basso. Si parla (secondo gli ultimi dati) di 258 decessi su un totale di circa 10mila casi. La percentuale, quindi, si attesta poco oltre il 2%. Ricordiamo che il tasso di mortalità di una normale influenza è solitamente compreso tra l'1 ed il 2 % (quindi non molto diverso). E che invece la Sars ha avuto un tasso di mortalità del 30% e il temibile virus Ebola dal 25% al 90%).
Perché allora tutto questo allarme?
Il clamore mediatico che la questione sta suscitando e l'allarme sanitario sono dettati da principio di precauzione, in quanto ancora non si conoscono tutti gli aspetti della nuova malattia. A questo proposito citiamo una nota del Ministero della Salute:
Il Governo ha dichiarato lo Stato di Emergenza Sanitaria
Il 31 gennaio il Consiglio dei ministri ha dichiarato lo stato di emergenza sanitaria per l’epidemia da nuovo coronavirus. La decisione è stata assunta subito dopo che l'OMS ha dichiarato l’emergenza di sanità pubblica di interesse internazionale.
“Alla luce della dichiarazione di emergenza internazionale dell’OMS abbiamo attivato gli strumenti normativi precauzionali previsti nel nostro Paese in questi casi, come già avvenuto nel 2003 in occasione dell’infezione Sars.” Queste le parole del ministro della Salute, Roberto Speranza, al termine della seduta del Consiglio dei Ministri.
E ancora, sempre dal Ministero della Salute:
L’Italia sin dalle prime fasi dell’epidemia, ispirandosi al principio di precauzione, ha implementato già prima della sospensione dei voli da parte della Cina controlli aeroportuali per i cittadini provenienti dalla zona sede del focolaio epidemico e attuato accurate misure di controllo: misurazione della temperatura corporea, identificazione ed isolamento dei malati, procedure per il rintraccio e la quarantena dei contatti stretti che, unitamente ad un efficiente sistema di sorveglianza epidemiologico e microbiologico, possano garantire il rapido contenimento di eventuali casi. È stata istituita dal 22 gennaio una Task force che si riunisce quotidianamente per coordinare, in raccordo continuo con le istituzioni internazionali competenti, tutte le azioni di controllo da assumere al fine di limitare la diffusione del virus e verificarne la rispondenza alle raccomandazioni dell’OMS. Inoltre è stato attivato 24 ore su 24 il numero di pubblica utilità 1500 dove operatori sanitari appositamente formati e mediatori culturali forniscono risposte alle domande dei cittadini e sono state diffuse locandine informative con consigli di prevenzione negli aeroporti. Dopo i casi confermati in Italia il 30 gennaio, il Governo italiano ha ritenuto opportuno interrompere i collegamenti con la Cina.
Ma quali sono i sintomi?
Febbre, tosse e respiro affannoso, con un periodo di incubazione tra i 2 ed i 14 giorni dal contagio (la malattia si può manifestare però anche senza febbre in alcuni casi)
Cosa possiamo fare per difenderci?
Le raccomandazioni sono quelle che valgono anche per la comune influenza. Le cosa basilari come lavare spesso le mani o disinfettare gli oggetti di uso comune.
Come saranno rimpatriati i turisti cinesi rimasti in Italia dopo il blocco dei voli?
E' stato organizzato un ponte aereo che utilizzerà un aereo militare













